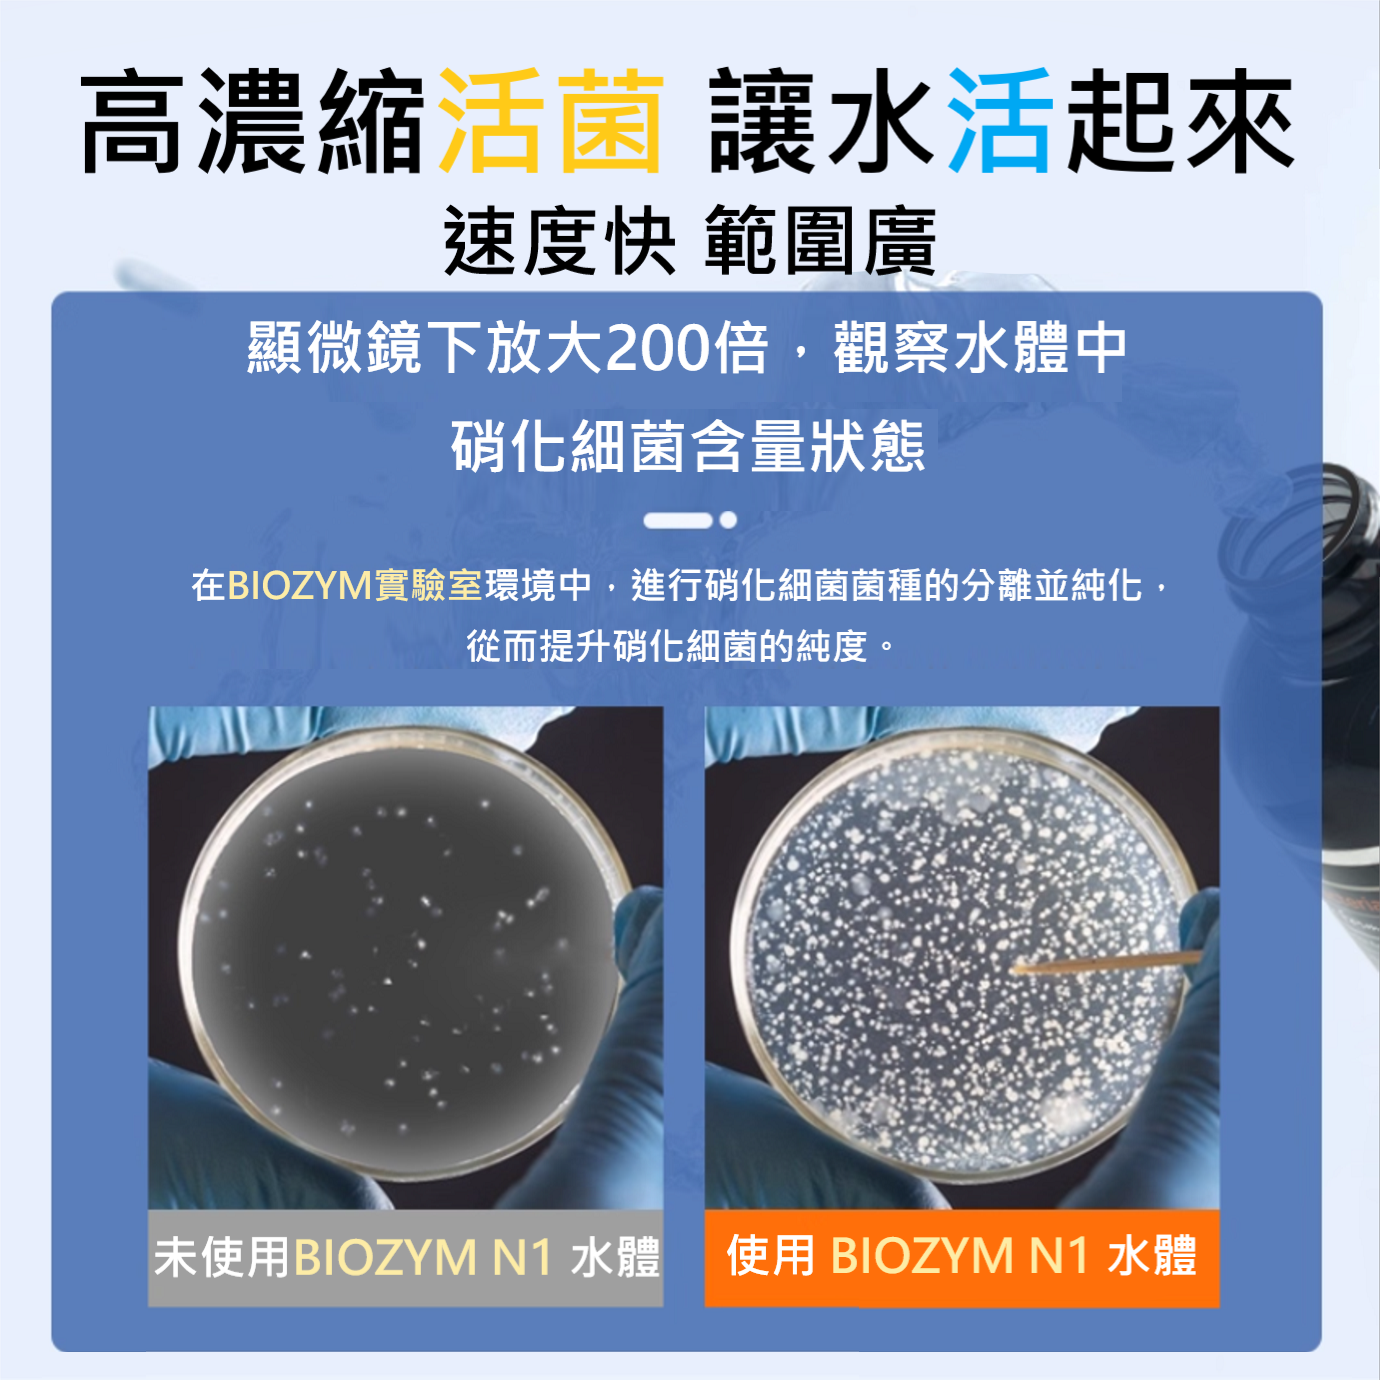

🎏 BIOZYM 百因美 硝化菌 膠囊 液體 高濃縮,水族 魚缸 換水 淡水 水草 龍魚 魟魚 錦鯉 池塘 皆有適用款。
- BIOZYM 百因美 膠囊 高濃縮 硝化菌 說明


- BIOZYM 百因美 N1 液體 高濃縮 硝化菌 說明

為完善您的購物體驗,iOPEN Mall 已於 2024 年 11 月 1 日更新「iOPEN Mall 服務條款」,並於 2024 年 11 月 21 日更新「隱私權政策」,相關條款及政策更新內容如下。如對本次調整有異議,得於 2025 年 12 月 31 日前,通知本公司終止契約。若未於前述期限前提出異議並通知本公司終止契約者,則視為同意。十分感謝您的支持,iOPEN Mall 將提供給您更優質的服務。
本 iOPEN Mall 服務條款(以下簡稱「服務條款」)適用於統一超商股份有限公司(以下簡稱「統一超商」或「本公司」)所建置之 iOPEN Mall 網站及應用程式(以下合稱「iOPEN Mall」或「本平台」)提供之電子商務平台服務(以下簡稱「本服務」)。在您開始使用本服務前,您必須閱讀並同意接受本服務條款、本服務之隱私權政策及本服務下所有條款與政策,以保障您的權益,如您不同意本服務條款、本服務之隱私權政策或本服務下所有條款與政策任一部分時,請勿使用或存取本服務。
本服務下 iOPEN Mall 為提供買家(以下簡稱「買家」)與賣家(以下簡稱「賣家」)(以下合稱「您」、「使用者」或「買賣雙方」)之間交易之電子商務平台,實際的買賣合約存在於買賣雙方,本公司或本平台並非該買賣合約的主體,亦不對該買賣合約承擔義務。買賣雙方將承擔買賣合約、商品刊登、商品瑕疵擔保及相關事項之全部責任。
本公司於本服務將根據隱私權政策所述方式收集、使用、揭露及處理您的個人資料,請參考本服務之隱私權政策以了解相關細節。
除前述各款所列情形以外,為保護本平台使用者或其他第三人之利益等原因,本公司得於合理期間前公告後暫時停止提供本平台服務之全部或一部。使用者因本服務停止衍生任何直接或間接之損失時,本公司不負任何賠償責任。
若本公司、本公司關係企業、或本公司及其關係企業之各自經理人、董事、員工、代表人或代理人,因您使用本服務或您違反本服務條款而面臨或產生任何第三方請求、損失、損害、和解程序、成本、費用、行政罰責或其他責任,您應為其抗辯、向其提供賠償,使其不因此受任何損害。
本服務、本平台及本服務條款之效力及解釋,以中華民國法律為準據法。除應適用法律另有規定外,基於本服務所生或與其有關之所有爭議與歧見,均應以台灣台北地方法院為第一審管轄法院。
本隱私權政策(以下稱「隱私權政策」)適用於統一超商股份有限公司(以下簡稱「統一超商」、「本公司」或「我們」)所建置之 iOPEN Mall 網站及應用程式(以下合稱「iOPEN Mall」或「本平台」)提供之電子商務平台服務(以下簡稱「本服務」)。本公司瞭解使用本服務的買家與賣家(以下合稱「您」或「使用者」)提供給我們的個人資料極為重要,並認真看待個人隱私權及個人資料保護相關法律規範下的責任。請參考本隱私權政策以瞭解我們在本服務如何蒐集、處理及利用您的個人資料。
本服務僅提供予居住在中華民國台澎金馬地區且具會員帳戶之使用者使用,尚無提供前述地區以外(例如:歐盟/歐洲經濟區)之居民使用。若您使用或存取本服務,即代表您同意本隱私權政策之內容,並同意本公司蒐集、處理及利用您的個人資料。若您不同意本隱私權政策下全部或一部之條款內容,請勿使用或存取本服務。本公司得變更本隱私權政策,本公司將於本平台公告變更後之隱私權政策內容。在適用法律允許的範圍內,若您於公告變更後繼續使用本服務,您將被視為同意接受修訂後之隱私權政策。
本公司將於下列情形蒐集使用者的個人資料:
本公司將僅於提供本服務之必要範圍內蒐集使用者的個人資料,包括以下類別:
本公司將於下列目的利用使用者的個人資料:
本公司將持續使用使用者的個人資料至使用者要求停止使用或本服務停止提供服務之日止。
本公司就使用者的個人資料之使用區域為台灣、日本(系統供應商雲端主機所在地)、愛爾蘭(服務供應商雲端主機所在地)及未受法令禁止之國際傳輸地點。
本公司可能會將使用者的個人資料傳輸與下列對象:
我們有時可能會執行「Cookie」或其他功能,讓我們或我們委託的第三方能夠蒐集或分享資訊,進而協助我們改進本服務,或是協助我們提供新的服務及功能。「Cookie」是我們傳送至您的電腦或行動裝置的識別碼,可以讓我們識別您的電腦或裝置,同時告訴我們本服務或網站的使用或造訪方式及時間、造訪人次,並追蹤我們網站中的活動。 我們可能會將「Cookie」資訊與個人資料連結起來。「Cookie」也會連結至您選擇購買之商品及您有檢視之網頁的相關資訊。這項資訊會用於追蹤您的購物車等用途。「Cookie」也用於傳遞與您興趣相關的特定內容,以及監控網站的使用情形。若您要拒絕「Cookie」的使用,請選擇瀏覽器上的適當設定。不過請注意,如果您這麼做,可能無法使用本服務的完整功能。
您的個人資料均被嚴密地保存在資料庫系統中。同時,任何人均需在本公司訂定之資料授權管理規範下,進行資料之取得與使用,而不在授權範圍內之任何人,均不得亦無法通過授權控管系統而取得資料。本公司並以Secure Sockets Layer(SSL)機制進行資料傳輸的加密,並已加裝防火牆防止不法入侵,避免您的個人資料遭到非法存取。儘管有前述對個人資料的管制及保護措施,仍無法保證絕對安全。提醒您應自行確實保管所使用之裝置、設備及帳號、密碼等登入資訊,避免個人資料受不法侵害。本公司將盡力以合理之技術及程序,保障您所有個人資料之安全。
本公司將按照個人資料保護法及/或其他適用法律,於蒐集目的所需之合理期間內保留個人資料。除法律另有規定之情況者外,當個人資料的保存期限屆滿或蒐集、處理或利用之目的達成時,本公司將刪除或銷毀該個人資料。
您得請求查詢、閱覽、複製、更正或補充、停止蒐集處理或利用或刪除本公司所持有之您的個人資料。惟上述權利,若因您不符合申請程序或法律規定,或本公司依法負有保存義務,或法律另有規定之情況者,則不在此限。您得自由行使相關權利,惟若提供之資料不足或有誤時或拒絕提供個人資料,本服務則可能將無法提供完整之功能。
若您拒絕接受客製化行銷或精準行銷時,本公司將立即停止利用您的個人資料從事該類行銷,但您仍可能收到來自本公司的一般廣告。
若欲行使上述任何權利,請聯繫本服務客服中心:
為嘗試提供更多元的服務內容,我們可能會選擇將各種第三方網站連結至本平台,或是將第三方網站放在本平台框架中。我們無法保證您在第三方網站上提供之個人資料或其他資訊的安全性,我們對於這些連結網站也沒有控制權,因此我們對於這些第三方網站的內容、安全措施及活動,並無任何責任或義務,且所連結的第三方網站有個別和獨立的隱私權政策及安全措施,請您參閱後再決定是否使用或存取第三方網站。若您決定使用或存取第三方網站,應自行承擔相關風險。我們可能不會收到由聯合品牌夥伴或第三方網站(即使是在本平台上或透過本平台提供) 所蒐集的資料。
本公司得變更本隱私權政策,本公司將於本平台公告變更後之政策。若您於公告變更後繼續使用本服務,您將被視為同意接受修訂後之隱私權政策內容。
最後更新日期:2024年11月21日
此商品暫時沒有評價